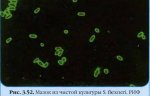

Инфекционный мононуклеоз - это вирусное заболевание, которое характеризуется повышением температуры, увеличения лимфатических узлов, так же происходят изменения в анализах крови. Заболевание возникает из-за вируса герпеса IV типа, по другому его называют Эпштейна-Барр, ученые, которые открыли его. Еще одно его название поцелуйной болезнью, так как болезнь может перейти во время поцелуя.
Грибковые инфекции бывают достаточно различные, но наиболее вероятны поражения кожи и ногтей - микозы и онихомикозы. Они заразны, передаются от человека к человеку. Пути заражения С жалобами на грибок обращаются люди любого возраста, как дети, так и взрослые, причем за последние десять лет заболеваемость среди большинства детей и подростков возросла. Заражение чаще всего имеет место в семье -
Атрофический тип солнечного кератоза характеризуется атрофией эпидермиса, незначительным гиперкератозом, атипией клеток базального слоя, наличием узких акантолитических тяжей в поверхностных отделах дермы. Нередко над базальным слоем эпидермиса обнаруживаются щели и лакуны, что напоминает болезнь Дарье. Атипичный базальный слой может также окружать в виде клеточной мантии верхнюю часть
С приходом осени резко возрастает количество острых респираторных заболеваний, а также встает более серьезная проблема – грипп. В период эпидемии необходимо избегать мест с большим скоплением людей, так как грипп передается воздушно-капельным путем, соблюдать чистоту в доме, регулярно проветривать помещения, делать влажную уборку, для этого идеально подойдут пылесосы Samsung с аквафильтром.
В настоящее время дизентерийные микробы объединены в род Shigella, семейства Enterobactereacea. По современной классификации род Shigella разделен всего на 4 вида. У всех шигелл в состав микробной клетки входит так называемый глюцидо-липидо-протеиновый комплекс, обладающий выраженными общими токсическими свойствами. Этот комплекс получил название эндотоксина. Один вид S. dysenterie 1 (прежнее
Применение термина ,,шок" как это ни странно, обусловило многочисленные противоречия, главным образом, в связи с субстратом, который ему приписывается. Этому содействовали, с одной стороны, клинические явления общие для шока любой этиологии (артериальная гипотония, снижение периферического кровотока и метаболические расстройства), что благоприятствовало пренебрежению этиологических особенностей,
Активные очаги клещевого риккетсиоза распространены преимущественно в азиатской части России и Казахстана. Эта инфекция зарегистрирована на 16 административных территориях юга Сибири и Дальнего Востока. По данным 19941997 гг., наиболее высокие показатели заболеваемости клещевым риккетсиозом отмечались в Алтайском крае, Еврейской автономной области, республиках Алтай и Хакасия (более 30 на 100
Прогулки на природе благоприятно сказываются не только на здоровье, но и на настроении людей. Однако бывает и так, что из леса или парка мы приносим на себе небольших паразитов – клещей. Мало того что приносим кровопийцу, так еще и можем заболеть клещевым энцефалитом. Несмотря на динамичное развитие диагностических и профилактических мероприятий, к сожалению, такое заболевание до сих пор
Для многих, даже тех, кто не связан с медициной, понятно, что ранняя диагностика рака играет огромную роль в успешном лечении болезни. Чем быстрее будут обнаружены злокачественные образования в человеческом организме, тем безболезненнее и эффективнее произойдет лечение. Наши легкие – важнейший орган, от которого зависит качество жизни. Именно поэтому мы уделим внимание ранней диагностике
Многие часто видят такие термины, как половые инфекции, венерические заболевания, ЗППП заболевания, которые передаются половым путем. Однако многие владеют устаревшей информацией и не понимают о каких инфекциях идет речь. В этой статье я вам постараюсь рассказать о них. В первую очередь нужно разобраться с терминологией. Данную группу заболеваний лучше всего называть ЗППП. Заболевания, которые
|